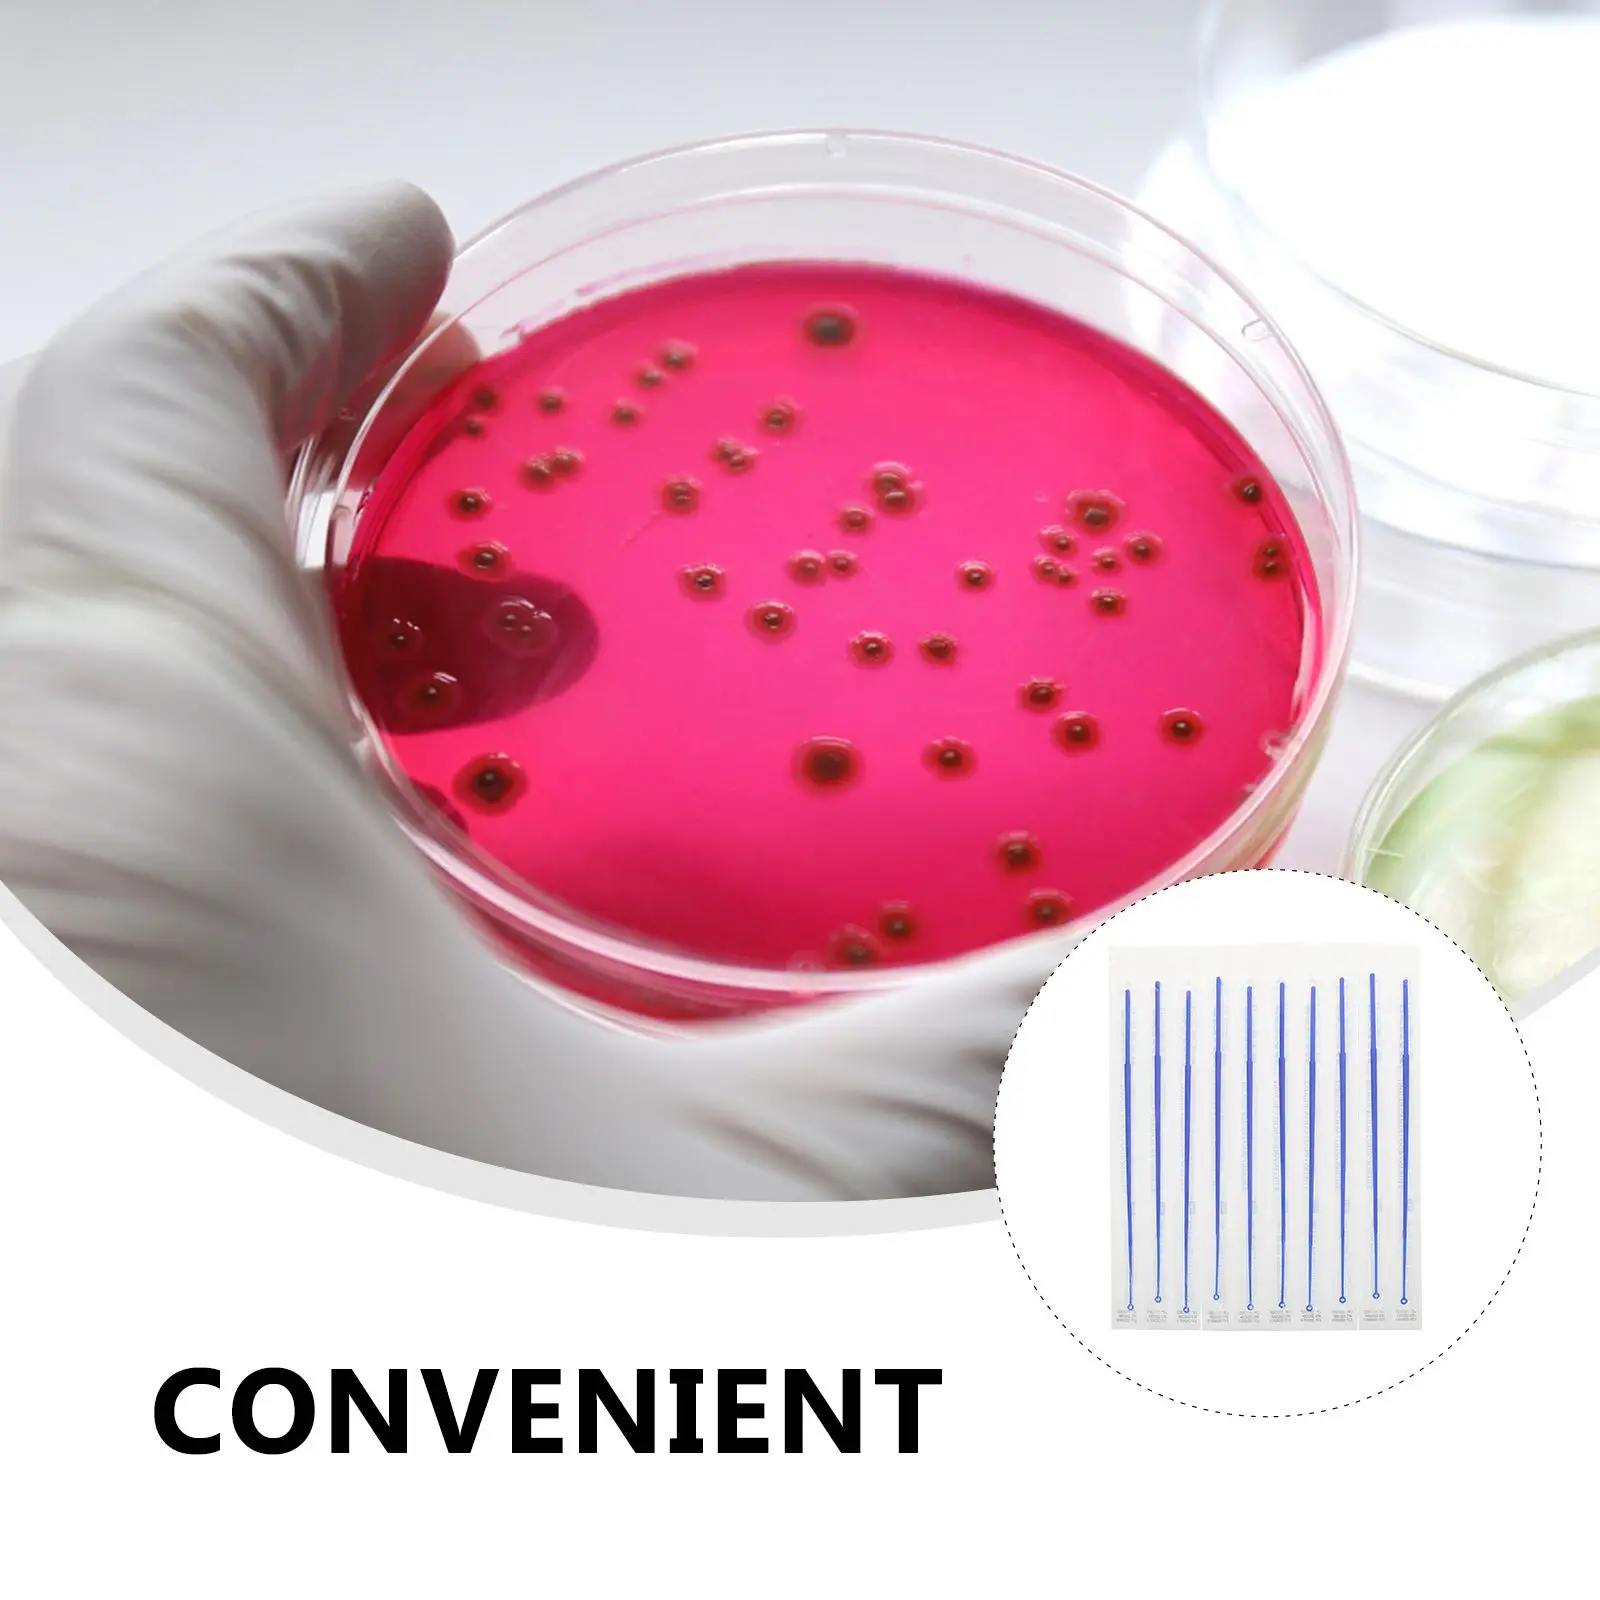
thumb
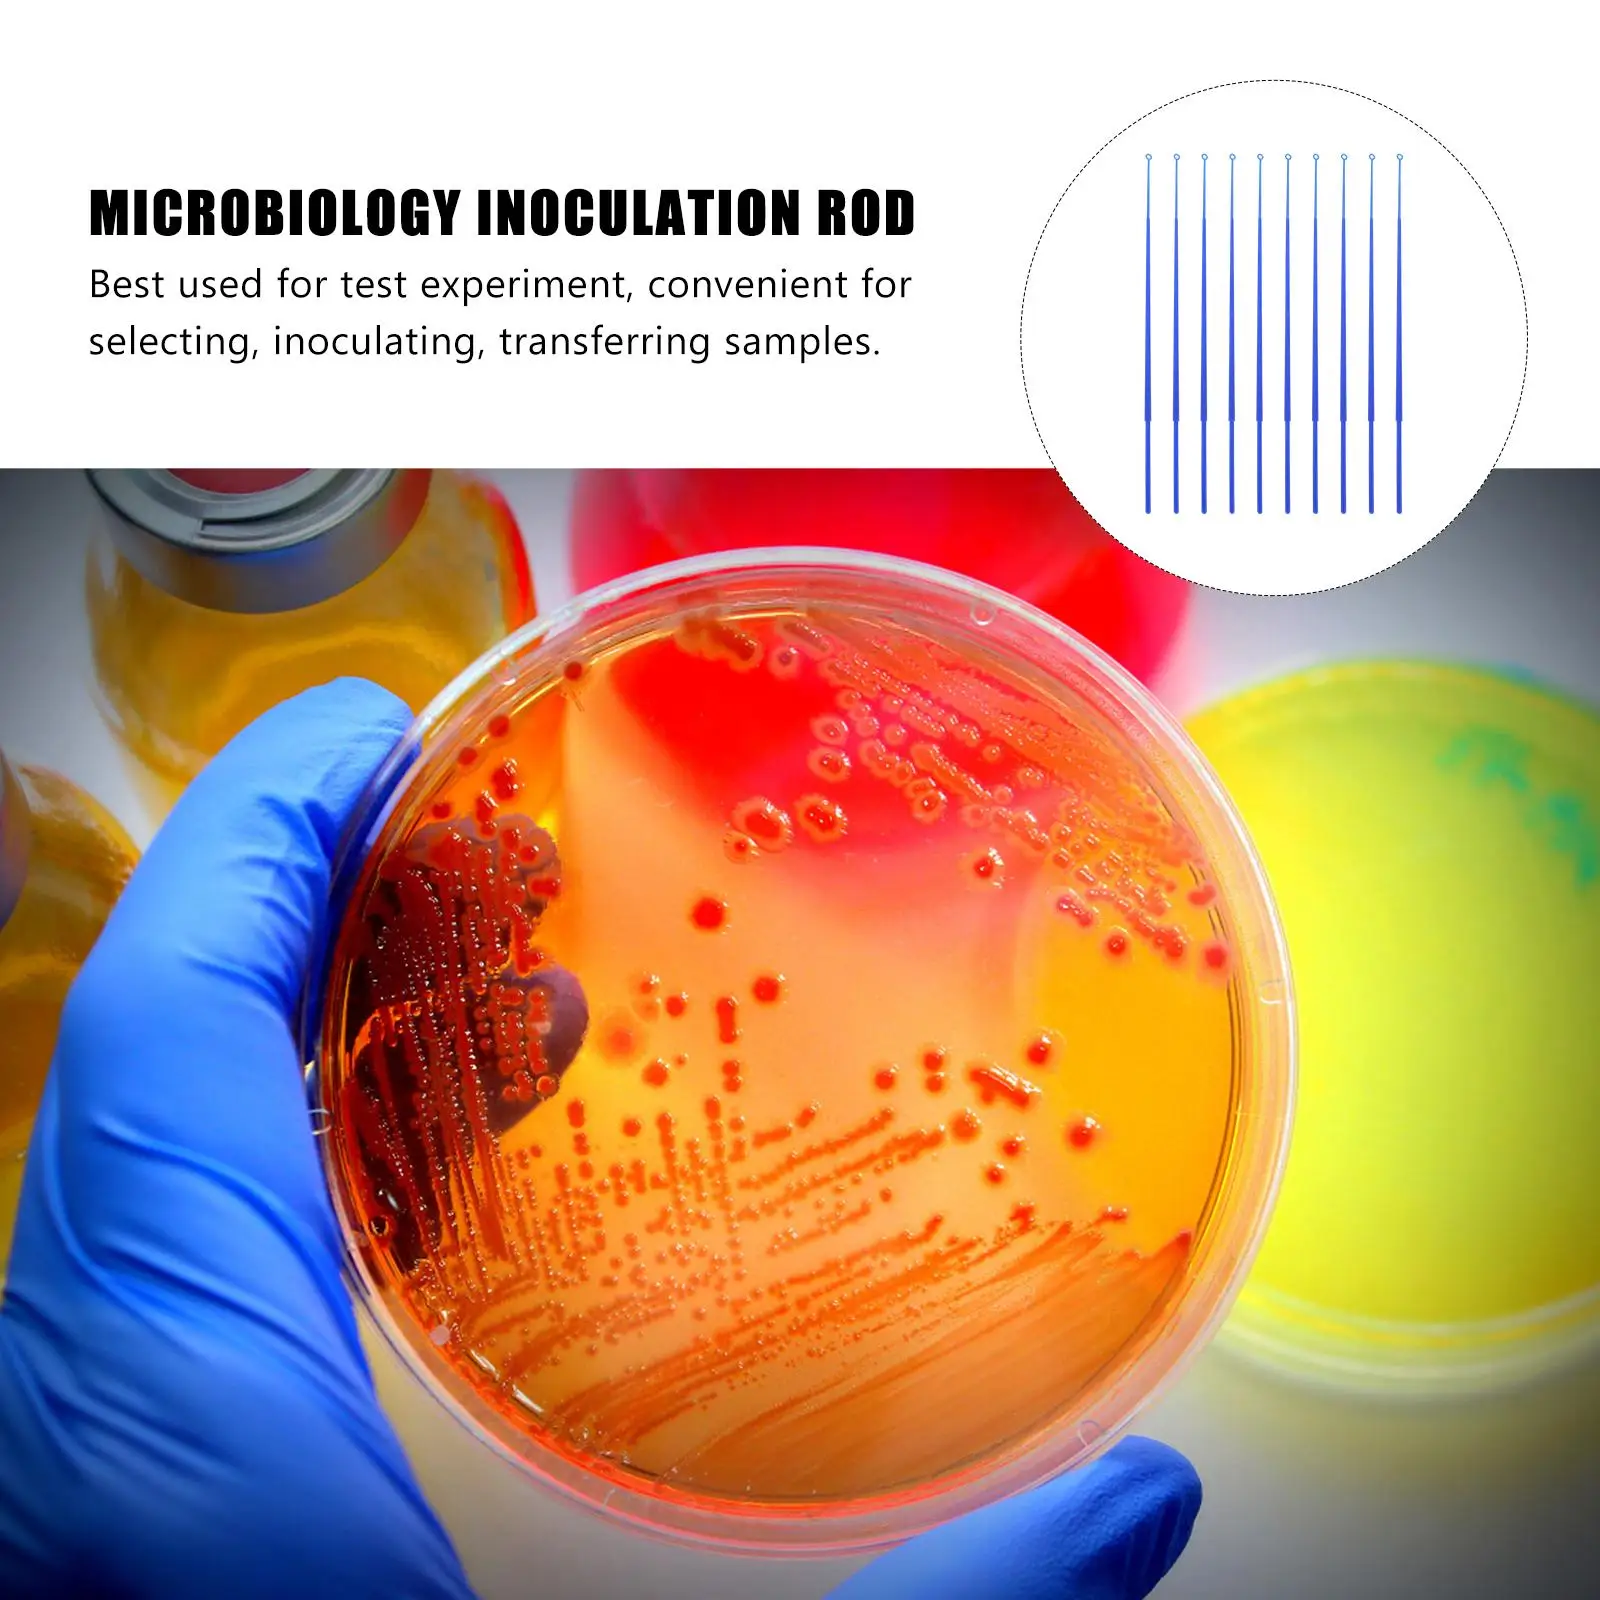
thumb

20 Pcs Inoculation Rods Disposable Microbiology Tools 5ul Sampling Sticks Lab Experiment Accessory Heat Resistant Stable
Price history chart & currency exchange rate
Customers also viewed

$85.23
Африканская кружевная ткань 2024, кружевная ткань ручной работы из бисера, французская блестящая нигерийская вышивка, сетчатая кружевная ткань для свадебного платья, шитье
aliexpress.ru
$1.33
Очень широкий пояс для женщин из искусственной кожи, бандажный корсет, пояс, европейский готический пояс с завязками на узле, декоративное платье «сделай сам»
aliexpress.ru
$12.62
5 упаковок свадебных носовых платков, ужина, событий, карманов, легкий квадратный платок, аксессуары для костюмов, новинка
aliexpress.ru
$8.21
Женская Винтажная Футболка The Great Dreamer в стиле Хэллоуина, мягкая летняя футболка с коротким рукавом и принтом в стиле ретро
aliexpress.ru
$61.45
Чернильная ручная роспись, крышка крана, чаша, керамическая чаша для домашнего чая, бутадиен, тонкая ручная чаша для младенцев
aliexpress.ru
$482.05
(по индивидуальному заказу) Лидер продаж MINISO стиль плавающая настенная полка деревянная стальная система стеллажей для розничного магазина полки для супермаркетов Bout
aliexpress.ru
$1,043.02
Настольный Токарный мини-станок CT125, сверлильный и фрезерный станок, 220 В, многофункциональный токарный станок, преподавательный станок, многофункциональный токарный станок, 1 шт.
aliexpress.ru
$609.35
Waterproof High Quality Tonneau Cover 4x4 Roller lid Shutter For GWM Fengjun 5/6/7 With Roll Bar Sports Bar
aliexpress.com
$208.89
Original Medicos Anime Action Figure Statue Legend JoJo Bizarre Adventure Part 3 Death Thirteen & Mannish Boy Assembly Model Kit
aliexpress.com
$58.14
Soccer Shoes for Men Outdoor Non Slip Training Football Boots Turf Soccer Cleats Breathable Children's Football Shoes
aliexpress.com
$15.60
MAC Cosmetics Matte Lipstick помада з матуючим ефектом відтінок Natural Born Leader
parfumeria.ua
$65.10
2020 men's polo shirt designer men brand england style fashion luxury short sleeve mens clothes popular t letters pattern breathable sh, White;black
dhgate.com
$6.51
Women Envelope Soft PU Leather Waist Female Pack Solid Casual Belt Bag Multifunctin Portable Chest Bag Girls Fanny Pack Lady
aliexpress.com
$24.75
designer bee copper crystal bracelet diamond vintage gold with box perfect for men and women gift giving 1121a209j2545001, Golden;silver
dhgate.com
$8.15
Разъем питания постоянного тока с кабелем для ноутбука HP CQ35 CQ36 DV3 DV3-2000 DC301006C00
aliexpress.ru
$16.28
African Dresses for Women Autumn Winter African Women Half Sleeve V-neck Polyester Solid Color Long Dress Maxi Dress L-3XL
aliexpress.ru
$12.77
Корректирующее нижнее белье для коррекции осанки, тонизирующее нижнее белье, корректирующая компрессионная Мужская футболка для контроля ...
aliexpress.ru
$6.99
Original with logo ZST V80 ES4 Case earphone Box Bluetooth Headset case Square Portable Compression Headset case EVA Zipper case
aliexpress.ru
$4.33
Pitcherwater Lidtea Spoutpitchersfor Beverage Iced Drink Handle Jug Gallon Kettle Lemonade Fridge Cold Filter Pot Large Clear
aliexpress.ru
$0.95
Flower Mirror Wall Stickers Diy Acrylic 3D Decorative Miroir Mural For Home Living Room Bedroom Decor
aliexpress.ru
$75.14
1 пара автомобильных светодиодных противотуманных фар, хосветильник огни s DRL с проводкой для Chevy Silverado 1500 2019-2021, проходящие Противотуманные ф...
aliexpress.ru
$119.00
Real Mink Fur Slippers Summer Fashion Fluffy Slides Women Indoor Outdoor Sandals Open Toe Flip Flops 2021 New Arrival
aliexpress.com
$14.29
250pcs(1roll) Archery Target Paper Shooting Practice Target Sticker 2inch Self-adhesive Target Paper Bow And Arrow Accessories
aliexpress.com
$1.76
TV Remote Controller Cover Remote Protector for Xiaomi 4S XMRM-010 X10 X6 MI 4S Protector Cover
aliexpress.com
$3.54
24 Sets Woodland Baby Shower Cupcake Wrappers and Toppers Deer Birthday Party Decorations Wild One Christmas Party Supplies
aliexpress.com
$2,580.00
Portable 2 in 1 Weight loss Radio Frequency Fat Reduction ultrasound cavitation slimming for Face Body therapy Machine
aliexpress.com
$58.65
BanDai 1/144 RG EVANGELION-01 NEON GENESIS EVANGELION EVA Action Chart Out of Print Rare Spot Kids Assembled Toy Gifts
aliexpress.com
$47.66
2018 4 4s Basketball Shoes men 4s Pure Money Royalty White Cement Premium Black Bred Fire Red mens Sports Sneakers size 8-13
dhgate.com
$6.84
Women Skinny Ripped Holes Jeans High Waist Punk Pants Skinny Slim Tight Lace Up Gothic Leggings Trousers OOA3459
dhgate.com
$16.79
New Women Sexy Leopard Print Bodycon Party Dress Slim Deep V Night Club midi Dresses Long sleeve Club Wear
dhgate.com